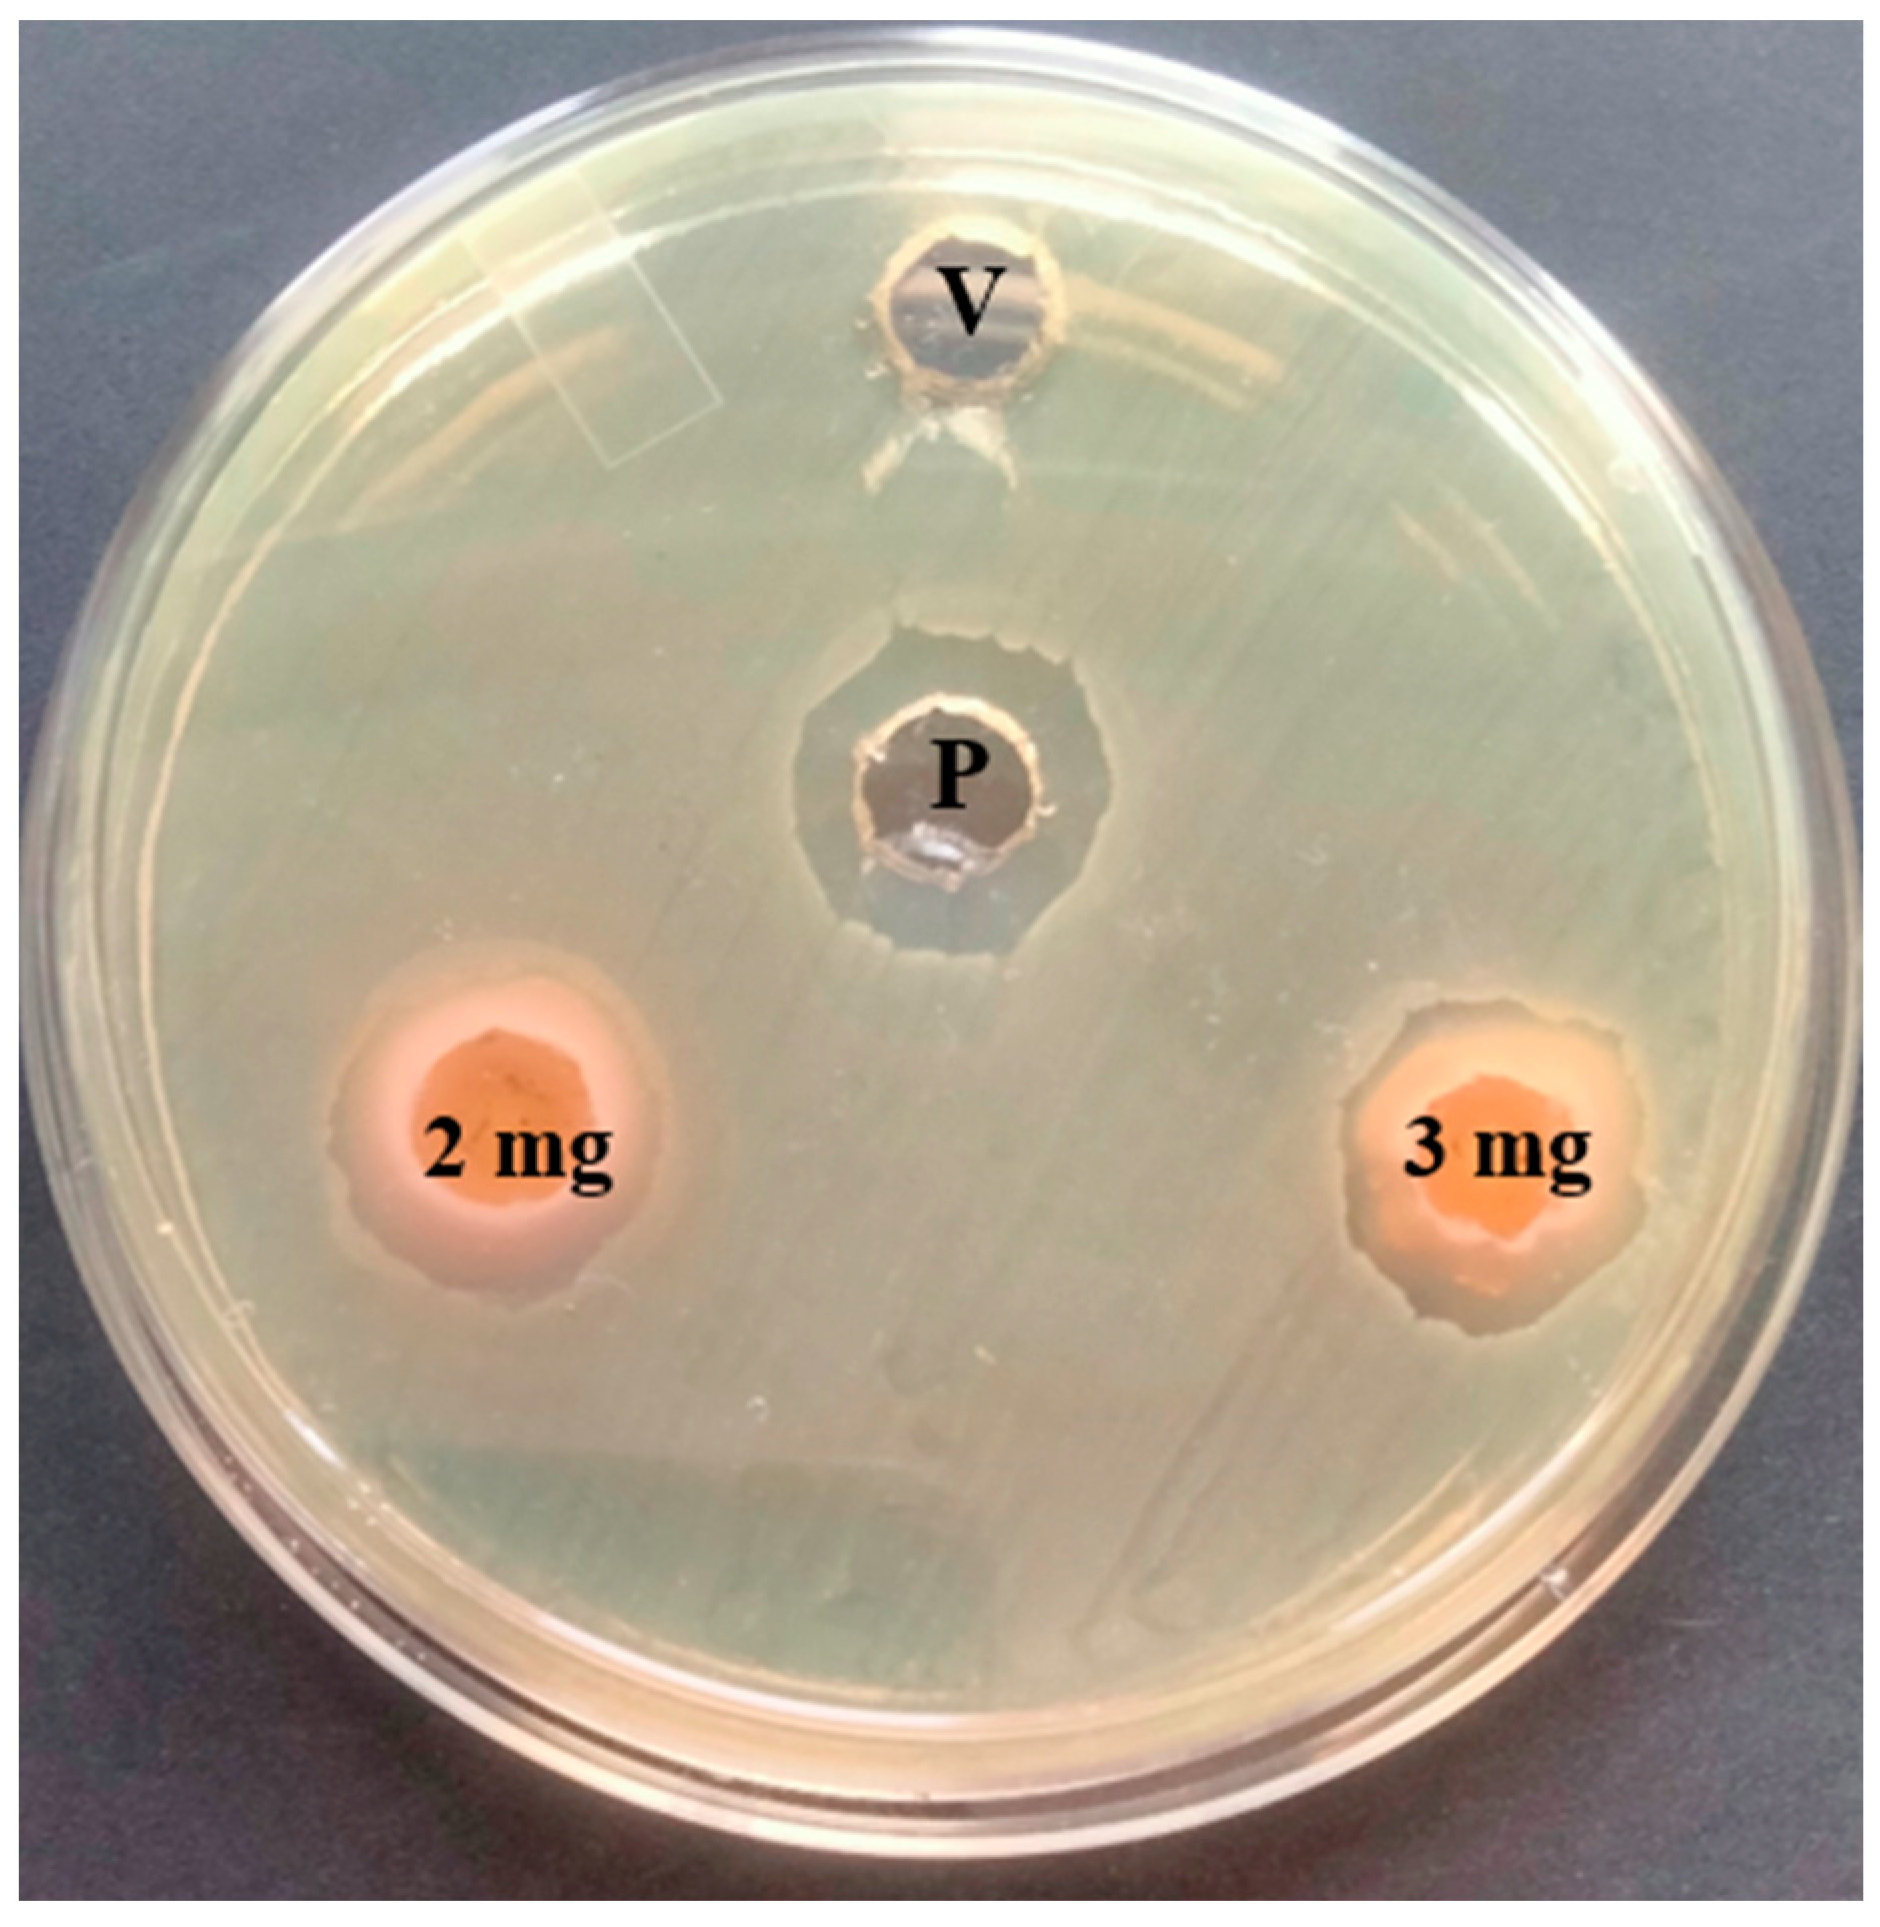
Life 14 01593 g002
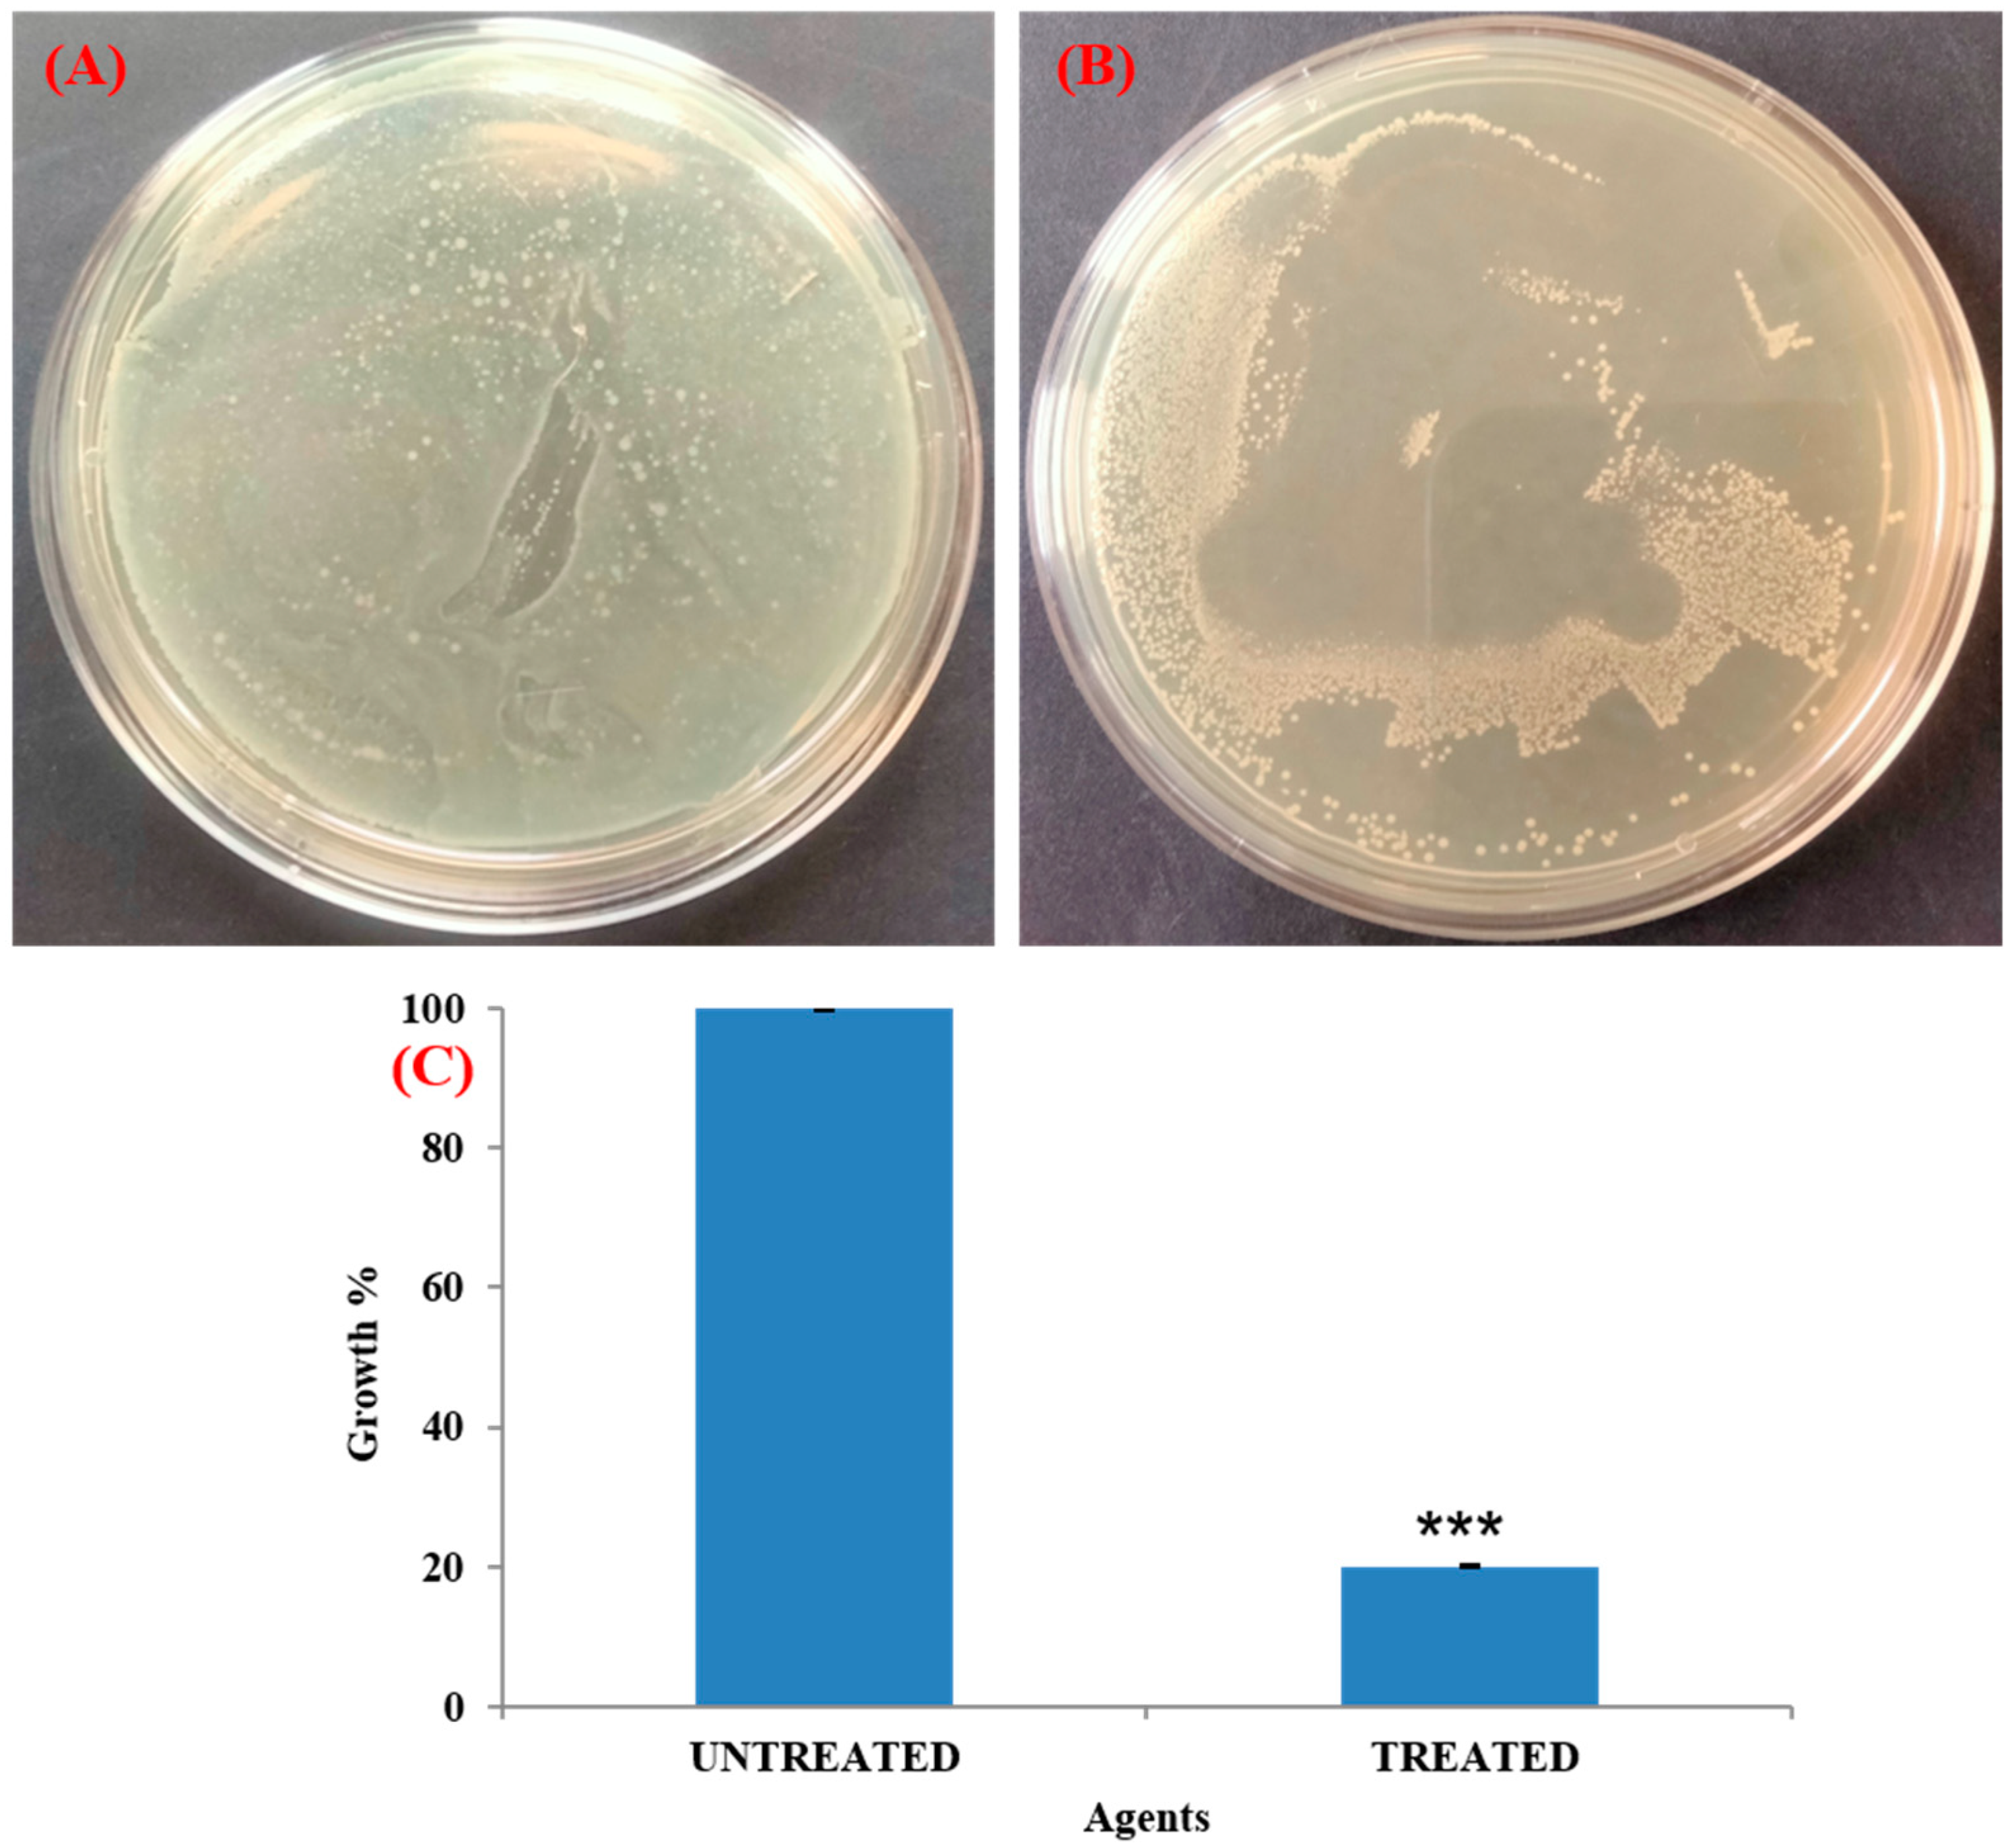
Life 14 01593 g009

Eradication of Biofilms on Catheters: Potentials of Tamarix ericoides Rottl. Bark Coating in Preventing Catheter-Associated Urinary Tract Infections (CAUTIs)
Abstract
1. Introduction
2. Materials and Methods
2.1. Chemicals and Preparation of Inoculum
2.2. Preparation of T. ericoides Bark Methanolic Extract
2.3. GC-MS Profiling of T. ericoides Bark Methanolic Extract
2.4. Antibacterial Activity of T. ericoides Bark Methanolic Extract
2.5. Determination of MIC of T. ericoides Bark Methanolic Extract
2.6. Time–Kill Effect of T. ericoides Bark Extract
2.7. Effect of T. ericoides Bark Extract on E. faecalis Biofilm Formation
2.8. Effect T. ericoides Bark Extract on Eradication of Biofilms by E. faecalis
2.9. T. ericoides Extract-Coated In Vitro Bladder Model
2.10. Quantification of Bacterial Load on In Vitro Bladder Model
2.11. Visualization of Biofilms on Bladder Model
2.12. Effect of T. ericoides Bark Extract on E. faecalis Cell Morphology
2.13. Cytotoxicity of T. ericoides Bark Extract
2.14. Statistical Analysis
3. Results
3.1. GC-MS Profiling of T. ericoides Bark Methanolic Extract
3.2. Antibacterial Activity of T. ericoides Bark Methanolic Extract
3.3. MIC Determination for T. ericoides Bark Methanolic Extract
3.4. Time–Kill Assay of T. ericoides Bark Extract
3.5. Effect of T. ericoides Bark Extract on E. faecalis Biofilm Formation
3.6. Eradication Effect of T. ericoides Bark Extract on E. faecalis Biofilm
3.7. Antibacterial Activity of T. ericoides Bark Extract-Coated Catheter
3.8. Visualization of Biofilm on Bladder Model
3.9. Impact of T. ericoides Bark Extract on E. faecalis Morphology
3.10. Cytotoxicity of T. ericoides Bark Extract
4. Discussion
5. Conclusions
Author Contributions
Funding
Institutional Review Board Statement
Informed Consent Statement
Data Availability Statement
Conflicts of Interest
References
- Stickler, D.J. Clinical Complications of Urinary Catheters Caused by Crystalline Biofilms: Something Needs to Be Done. J. Intern. Med. 2014, 276, 120–129. [Google Scholar] [CrossRef] [PubMed]
- Skelton-Dudley, F.; Doan, J.; Suda, K.; Holmes, S.A.; Evans, C.; Trautner, B. Spinal Cord Injury Creates Unique Challenges in Diagnosis and Management of Catheter-Associated Urinary Tract Infection. Top. Spinal Cord Inj. Rehabil. 2019, 25, 331–339. [Google Scholar] [CrossRef] [PubMed]
- Medina, M.; Castillo-Pino, E. An Introduction to the Epidemiology and Burden of Urinary Tract Infections. Ther. Adv. Urol. 2019, 11, 1756287219832172. [Google Scholar] [CrossRef] [PubMed]
- Wooller, K.R.; Backman, C.; Gupta, S.; Jennings, A.; Hasimja-Saraqini, D.; Forster, A.J. A Pre and Post Intervention Study to Reduce Unnecessary Urinary Catheter Use on General Internal Medicine Wards of a Large Academic Health Science Center. BMC Health Serv. Res. 2018, 18, 642. [Google Scholar] [CrossRef]
- Saint, S.; Greene, M.T.; Krein, S.L.; Rogers, M.A.; Ratz, D.; Fowler, K.E.; Edson, B.S.; Watson, S.R.; Meyer-Lucas, B.; Masuga, M.; et al. A Program to Prevent Catheter-Associated Urinary Tract Infection in Acute Care. N. Engl. J. Med. 2016, 374, 2111–2119. [Google Scholar] [CrossRef]
- Guggenbichler, J.P.; Assadian, O.; Michael, B.; Axel, K. Incidence and Clinical Implication of Nosocomial Infections Associated with Implantable Biomaterials: Catheters, Ventilator-Associated Pneumonia, Urinary Tract Infections. GMS Krankenhaushygiene Interdiszip. 2011, 6, Doc18. [Google Scholar] [CrossRef]
- Milo, S.; Nzakizwanayo, J.; Hathaway, H.J.; Jones, B.V.; Jenkins, A.T.A. Emerging Medical and Engineering Strategies for the Prevention of Long-Term Indwelling Catheter Blockage. Proc. Inst. Mech. Eng. Part H J. Eng. Med. 2019, 233, 68–83. [Google Scholar] [CrossRef]
- Papanikolopoulou, A.; Maltezou, H.C.; Stoupis, A.; Kalimeri, D.; Pavli, A.; Boufidou, F.; Karalexi, M.; Pantazis, N.; Pantos, C.; Tountas, Y. Catheter-Associated Urinary Tract Infections, Bacteremia, and Infection Control Interventions in a Hospital: A Six-Year Time-Series Study. J. Clin. Med. 2022, 11, 5418. [Google Scholar] [CrossRef]
- Flores-Mireles, A.; Hreha, T.N.; Hunstad, D.A. Pathophysiology, Treatment, and Prevention of Catheter-Associated Urinary Tract Infection. Top. Spinal Cord Inj. Rehabil. 2019, 25, 228–240. [Google Scholar] [CrossRef]
- Oumer, Y.; Dadi, B.R.; Seid, M.; Biresaw, G.; Manilal, A. Catheter-Associated Urinary Tract Infection: Incidence, Associated Factors and Drug Resistance Patterns of Bacterial Isolates in Southern Ethiopia. Infect. Drug Resist. 2021, 14, 2883–2894. [Google Scholar] [CrossRef]
- Di Martino, P. Extracellular Polymeric Substances, a Key Element in Understanding Biofilm Phenotype. AIMS Microbiol. 2018, 4, 274–288. [Google Scholar] [CrossRef] [PubMed]
- Kurmoo, Y.; Hook, A.L.; Harvey, D.; Dubern, J.F.; Williams, P.; Morgan, S.P.; Korposh, S.; Alexander, M.R. Real-Time Monitoring of Biofilm Formation on Coated Medical Devices for the Reduction and Interception of Bacterial Infections. Biomater. Sci. 2020, 8, 1464. [Google Scholar] [CrossRef]
- Bjarnsholt, T. The Role of Bacterial Biofilms in Chronic Infections. APMIS Suppl. 2013, 121, 1–51. [Google Scholar] [CrossRef]
- Sharma, G.; Sharma, S.; Sharma, P.; Chandola, D.; Dang, S.; Gupta, S.; Gabrani, R. Escherichia coli Biofilm: Development and Therapeutic Strategies. J. Appl. Microbiol. 2016, 121, 309–319. [Google Scholar] [CrossRef]
- Codelia-Anjum, A.; Lerner, L.B.; Elterman, D.; Zorn, K.C.; Bhojani, N.; Chughtai, B. Enterococcal Urinary Tract Infections: A Review of the Pathogenicity, Epidemiology, and Treatment. Antibiotics 2023, 12, 778. [Google Scholar] [CrossRef]
- Jonathan, A.; Sandoe, T.; Ian, R.; Witherden, H.K.; Au-Yeung, C.; Peter, K.; Kevin, G.; Kerr, M.; Wilcox, H. Enterococcal intravascular catheter-related bloodstream infection: Management and outcome of 61 consecutive cases. J. Antimicrob. Chemother. 2002, 50, 577–582. [Google Scholar] [CrossRef]
- Guiton, P.S.; Hannan, T.J.; Ford, B.; Caparon, M.G.; Hultgren, S.J. Enterococcus faecalis overcomes foreign body-mediated inflammation to establish urinary tract infections. Infect. Immun. 2013, 81, 329–339. [Google Scholar] [CrossRef] [PubMed]
- Xu, W.; Flores-Mireles, A.L.; Cusumano, Z.T.; Takagi, E.; Hultgren, S.J.; Caparon, M.G. Host and bacterial proteases influence biofilm formation and virulence in a murine model of enterococcal catheter-associated urinary tract infection. npj Biofilms Microbiomes 2017, 3, 28. [Google Scholar] [CrossRef]
- Flores-Mireles, A.L.; Walker, J.N.; Potretzke, A.; Schreiber, H.L.; Pinkner, J.S.; Bauman, T.M.; Park, A.M.; Desai, A.; Hultgren, S.J.; Caparon, M.G. Antibody-Based Therapy for Enterococcal Catheter-Associated Urinary Tract Infections. mBio 2016, 7, e01653-16. [Google Scholar] [CrossRef]
- Tien, B.Y.Q.; Goh, H.M.S.; Chong, K.K.L.; Bhaduri-Tagore, S.; Holec, S.; Dress, R.; Ginhoux, F.; Ingersoll, M.A.; Williams, R.B.H.; Kline, K.A. Enterococcus faecalis Promotes Innate Immune Suppression and Polymicrobial Catheter-Associated Urinary Tract Infection. Infect. Immun. 2017, 85, e00378-17. [Google Scholar] [CrossRef]
- Tenke, P.; Mezei, T.; Bode, I.; Köves, B. Catheter-Associated Urinary Tract Infections. Eur. Urol. Suppl. 2017, 16, 138–143. [Google Scholar] [CrossRef]
- Peng, D.; Li, X.; Liu, P.; Luo, M.; Chen, S.; Su, K.; Zhang, Z.; He, Q.; Qiu, J.; Li, Y. Epidemiology of Pathogens and Antimicrobial Resistance of Catheter-Associated Urinary Tract Infections in Intensive Care Units: A Systematic Review and Meta-Analysis. Am. J. Infect. Control 2018, 46, e81–e90. [Google Scholar] [CrossRef]
- Walker, J.N.; Flores-Mireles, A.L.; Lynch, A.J.L.; Pinkner, C.; Caparon, M.G.; Hultgren, S.J. High-Resolution Imaging Reveals Microbial Biofilms on Patient Urinary Catheters Despite Antibiotic Administration. World J. Urol. 2020, 38, 2237–2245. [Google Scholar] [CrossRef]
- Maharjan, G.; Khadka, P.; Shilpakar, S.G.S.; Chapagain, G.; Dhungana, G.R. Catheter-Associated Urinary Tract Infection and Obstinate Biofilm Producers. Can. J. Infect. Dis. Med. Microbiol. 2018, 2018, 7624857. [Google Scholar] [CrossRef]
- Magill, S.S.; O’Leary, E.; Janelle, S.J.; Thompson, D.L.; Dumyati, G.; Nadle, J. Changes in Prevalence of Health Care-Associated Infections in U.S. Hospitals. N. Engl. J. Med. 2018, 379, 1732–1744. [Google Scholar] [CrossRef] [PubMed]
- Lim, K.; Chua, R.R.; Ho, B.; Tambyah, P.A.; Hadinoto, K.; Leong, S.S. Development of a catheter functionalized by a polydopamine peptide coating with antimicrobial and antibiofilm properties. Acta Biomater. 2015, 15, 127–138. [Google Scholar] [CrossRef] [PubMed]
- Chen, R.; Willcox, M.D.; Ho, K.K.; Smyth, D.; Kumar, N. Antimicrobial peptide melimine coating for titanium and its in vivo antibacterial activity in rodent subcutaneous infection model. Biomaterials 2016, 85, 142–151. [Google Scholar] [CrossRef]
- Pickard, R.; Lam, T.; MacLennan, G.; Starr, K.; Kilonzo, M.; McPherson, G.; Gillies, K.; McDonald, A.; Walton, K.; Buckley, B.; et al. Antimicrobial catheters for reduction of symptomatic urinary tract infection in adults requiring short-term catheterisation in hospital: A multicentre randomised controlled trial. Lancet 2012, 380, 1927–1935. [Google Scholar] [CrossRef]
- Milo, S.; Thet, N.T.; Liu, D.; Nzakizwanayo, J.; Jones, B.V.; Jenkins, A.T.A. An in-situ infection detection sensor coating for urinary catheters. Biosens. Bioelectron. 2016, 81, 166–172. [Google Scholar] [CrossRef]
- Campoccia, D.; Montanaro, L.; Speziale, P.; Arciola, C.R. Antibiotic-loaded biomaterials and the risks for the spread of antibiotic resistance following their prophylactic and therapeutic clinical use. Biomaterials 2010, 31, 6363–6377. [Google Scholar] [CrossRef]
- Van, H.N. The Use of Medicinal Plants as Immunostimulants in Aquaculture: A Review. Aquaculture 2015, 446, 88–96. [Google Scholar] [CrossRef]
- Sethi, J.; Singh, J. Role of Medicinal Plants as Immunostimulants in Health and Disease. Ann. Med. Chem. Res. 2015, 1, 1009–1013. [Google Scholar]
- Pieczykolan, A.; Pietrzak, W.; Dos Santos Szewczyk, K.; Dos Santos Szewczyk, U.; Nowak, R. LC-ESI-MS/MS Polyphenolic Profile and In Vitro Study of Cosmetic Potential of Aerva lanata (L.) Juss. Herb Extracts. Molecules 2022, 27, 1259. [Google Scholar] [CrossRef]
- WHO. WHO Global Report on Traditional and Complementary Medicine 2019; World Health Organization: Geneva, Switzerland, 2019; Available online: https://www.who.int/publications/i/item/978924151536 (accessed on 22 October 2024).
- Vaou, N.; Stavropoulou, E.; Voidarou, C.; Tsigalou, C.; Bezirtzoglou, E. Towards Advances in Medicinal Plant Antimicrobial Activity: A Review Study on Challenges and Future Perspectives. Microorganisms 2021, 9, 2041. [Google Scholar] [CrossRef]
- Almabruk, K.H.; Dinh, L.K.; Philmus, B. Self-Resistance of Natural Product Producers: Past, Present, and Future Focusing on Self-Resistant Protein Variants. ACS Chem. Biol. 2018, 13, 1426–1437. [Google Scholar] [CrossRef]
- AlSheikh, H.M.A.; Sultan, I.; Kumar, V.; Rather, I.A.; Al-Sheikh, H.; Tasleem, J.A.; Haq, Q.M.R. Plant-Based Phytochemicals as Possible Alternative to Antibiotics in Combating Bacterial Drug Resistance. Antibiotics 2020, 9, 480. [Google Scholar] [CrossRef]
- Cheesman, M.J.; Ilanko, A.; Blonk, B.; Cock, I.E. Developing New Antimicrobial Therapies: Are Synergistic Combinations of Plant Extracts/Compounds with Conventional Antibiotics the Solution? Pharmacogn Rev. 2017, 11, 57–72. [Google Scholar] [CrossRef]
- Bahramsoltani, R.; Kalkhorani, M.; Abbas Zaidi, S.M.; Farzaei, M.H.; Rahimi, R. The Genus Tamarix: Traditional Uses, Phytochemistry, and Pharmacology. J. Ethnopharmacol. 2020, 246, 112245. [Google Scholar] [CrossRef] [PubMed]
- Alshehri, S.A.; Wahab, S.; Abullais, S.S.; Das, G.; Hani, U.; Ahmad, W.; Amir, M.; Ahmad, A.; Kandasamy, G.; Vasudevan, R. Pharmacological Efficacy of Tamarix aphylla: A Comprehensive Review. Plants 2021, 11, 118. [Google Scholar] [CrossRef]
- Harley, B.K.; Quagraine, A.M.; Neglo, D.; Aggrey, M.O.; Orman, E.; Mireku-Gyimah, N.A. Metabolite Profiling, Antifungal, Biofilm Formation Prevention and Disruption of Mature Biofilm Activities of Erythrina senegalensis Stem Bark Extract Against Candida albicans and Candida glabrata. PLoS ONE 2022, 17, e0278096. [Google Scholar] [CrossRef]
- Dubey, D.; Patnaik, R.; Ghosh, G.; Padhy, R.N. In Vitro Antibacterial Activity, Gas Chromatography-Mass Spectrometry Analysis of Woodfordia fruticosa Kurz. Leaf Extract and Host Toxicity Testing with In Vitro Cultured Lymphocytes from Human Umbilical Cord Blood. Osong Public Health Res. Perspect. 2014, 5, 298–312. [Google Scholar] [CrossRef] [PubMed]
- Meiyazhagan, G.; Winfred, S.B.; Jayashree, B.; Prabhu, D.; Raghavan, S.; Surabi, R.P.; Ravishankar, P.; Deivanayagam, K.; Ragavachary, R.; Jeyaraman, J.; et al. β-Lactam Substituted Polycyclic Fused Pyrrolidine/Pyrrolizidine Derivatives Eradicate Candida albicans in an Ex Vivo Human Dentinal Tubule Model by Inhibiting Sterol 14-α Demethylase and cAMP Pathway. Biochim. Biophys. Acta 2016, 1860, 636–647. [Google Scholar] [CrossRef]
- Meiyazhagan, G.; Raju, R.; Winfred, S.B.; Mannivanan, B.; Bhoopalan, H.; Shankar, V. Bioactivity Studies of β-Lactam Derived Polycyclic Fused Pyrrolidine/Pyrrolizidine Derivatives in Dentistry: In Vitro, In Vivo and In Silico Studies. PLoS ONE 2015, 10, e0131433. [Google Scholar] [CrossRef]
- Goda, R.M.; El-Baz, A.M.; Khalaf, E.M.; Alharbi, N.K.; Elkhooly, T.A.; Shohayeb, M.M. Combating Bacterial Biofilm Formation in Urinary Catheter by Green Silver Nanoparticle. Antibiotics 2022, 11, 495. [Google Scholar] [CrossRef] [PubMed]
- Muthu, D.; Gowri, M.; Suresh Kumar, G.; Kattimani, V.S.; Girija, E.K. Repurposing of Antidepression Drug Sertraline for Antimicrobial Activity Against Staphylococcus aureus: A Potential Approach for the Treatment of Osteomyelitis. New J. Chem. 2019, 43, 5315–5324. [Google Scholar] [CrossRef]
- Gowri, M.; Jayashree, B.; Jeyakanthan, J.; Girija, E.K. Sertraline as a Promising Antifungal Agent: Inhibition of Growth and Biofilm of Candida auris With Special Focus on the Mechanism of Action in Vitro. J. Appl. Microbiol. 2020, 128, 426–437. [Google Scholar] [CrossRef] [PubMed]
- Jadhao, A.B.; Bhadange, D.G. In Vitro Antimicrobial Activity of Tamarix ericoides Rottl. Stem and Leaf Extract (Methanolic). Int. J. Sci. Res. (IJSR) 2013, 4, 264–265. [Google Scholar]
- Assiri, R.A.; El-Masry, T.A.; El-Haggar, S.M.; Elekhnawy, E.; Eldin, S.S.; El-Kadem, A.H.; Mostafa, S.A.; Elberri, A.I.; Magdeldin, S.; Negm, W.A.; et al. Phytochemical Investigation, Antibacterial, and Ameliorative Potential Effects of Tamarix nilotica on LPS-Induced Acute Lung Injury Model in Mice. Biomed. Pharmacother. 2023, 168, 115678. [Google Scholar] [CrossRef]
- Sobeai, A.; Anticancer, S.M. Cytotoxic Effect of Tamarix Aphylla, and Antibacterial Screening Efficiency Against Multidrug-Resistant Human Pathogens. Asian J. Pharm. Clin. Res. 2018, 11, 241. [Google Scholar] [CrossRef]
- Iqbal, H.; Ishfaq, M.; Abbas, M.N.; Ahmad, I.; Rehman, A.; Amin, S.B.; Shagufta, B.I.; Ullah, M. In Vitro Antimicrobial Study of Tamarix aphylla in View of Phytochemical Constituents. Pharmacologia 2015, 6, 333–336. [Google Scholar] [CrossRef]
- Khalid, M.; Hassani, D.; Bilal, M.; Butt, Z.A.; Hamayun, M.; Ahmad, A.; Huang, D.; Hussain, A. Identification of Oral Cavity Biofilm-Forming Bacteria and Determination of Their Growth Inhibition by Acacia arabica, Tamarix aphylla L., and Melia azedarach L. Medicinal Plants. Arch. Oral Biol. 2017, 81, 175–185. [Google Scholar] [CrossRef] [PubMed]
- Saïdana, D.; Mahjoub, M.A.; Boussaada, O.; Chriaa, J.; Chéraif, I.; Daami, M.; Mighri, Z.; Helal, A.N. Chemical Composition and Antimicrobial Activity of Volatile Compounds of Tamarix boveana (Tamaricaceae). Microbiol. Res. 2008, 163, 445–455. [Google Scholar] [CrossRef]
- Ksouri, R.; Falleh, H.; Megdiche, W.; Trabelsi, N.; Mhamdi, B.; Chaieb, K.; Bakrouf, A.; Magné, C.; Abdelly, C. Antioxidant and Antimicrobial Activities of the Edible Medicinal Halophyte Tamarix gallica L. and Related Polyphenolic Constituents. Food Chem. Toxicol. 2009, 47, 2083–2091. [Google Scholar] [CrossRef]
- Ren, X.; Bao, Y.; Peng, Z.; Liu, S.; Zhang, Z.; Zhou, G. Isorhamnetin, Hispidulin, and Cirsimaritin Identified in Tamarix ramosissima Barks From Southern Xinjiang and Their Antioxidant and Antimicrobial Activities. Molecules 2019, 24, 390. [Google Scholar] [CrossRef] [PubMed]
- Hegazi, A.G.; Guthami, F.M.A.; Ramadan, M.F.A.; Gethami, A.F.M.A.; Craig, A.M.; El-Seedi, H.R.; Rodríguez, I.; Serrano, S. The Bioactive Value of Tamarix gallica Honey from Different Geographical Origins. Insects 2023, 14, 319. [Google Scholar] [CrossRef]
- Alhourani, N.; Kasabri, V.; Bustanji, Y.; Abbassi, R.; Hudaib, M. Potential Antiproliferative Activity and Evaluation of Essential Oil Composition of the Aerial Parts of Tamarix aphylla (L.) H.Karst.: A Wild Grown Medicinal Plant in Jordan. Evid. Based Complement. Altern. Med. 2018, 2018, 9363868. [Google Scholar] [CrossRef]
- Ren, X.; Wang, W.; Bao, Y.; Zhu, Y.; Zhang, Z.; Lu, Y.; Peng, Z.; Zhou, G. Isorhamnetin and Hispidulin from Tamarix ramosissima Inhibit 2-Amino-1-Methyl-6-Phenylimidazo [4,5-b]Pyridine (PhIP) Formation by Trapping Phenylacetaldehyde as a Key Mechanism. Foods 2020, 9, 420. [Google Scholar] [CrossRef]
- Yao, X.T.; Ling, P.X.; Jiang, S.; Lai, P.X.; Zhu, C.G. Analysis of the Essential Oil from Gaillardia pulchella Foug. and Its Antioxidant Activity. J. Oleo Sci. 2013, 62, 329–333. [Google Scholar] [CrossRef] [PubMed]
- Sung, J.W.; Hsieh, S.Y.; Lin, C.L.; Leng, C.H.; Liu, S.J.; Chou, A.H.; Lai, L.W.; Lin, L.H.; Kwok, Y.; Yang, C.Y.; et al. Biochemical Characterizations of Escherichia coli-expressed Protective Antigen Ag473 of Neisseria meningitides Group B. Vaccine 2010, 28, 8175–8182. [Google Scholar] [CrossRef]
- Zhang, T.H.; He, H.X.; Du, J.L.; He, Z.J.; Yao, S. Novel 3-Methyl-2-alkylthio Benzothiazolyl-Based Ionic Liquids: Synthesis, Characterization, and Antibiotic Activity. Molecules 2018, 23, 2011. [Google Scholar] [CrossRef]
- Emam, S.H.; Hassan, R.A.; Osman, E.O.; Hamed, M.I.A.; Abdou, A.M.; Kandil, M.M.; Elbaz, E.M.; Mikhail, D.S. Coumarin Derivatives With Potential Anticancer and Antibacterial Activity: Design, Synthesis, VEGFR-2 and DNA Gyrase Inhibition, and In Silico Studies. Drug Dev. Res. 2023, 84, 433–457. [Google Scholar] [CrossRef] [PubMed]
- Zhu, Z.; Wang, Z.; Li, S.; Yuan, X. Antimicrobial Strategies for Urinary Catheters. J. Biomed. Mater. Res. Part A 2019, 107, 445–467. [Google Scholar] [CrossRef] [PubMed]
- Moglad, E.; Elekhnawy, E.; Negm, W.A.; Mokhtar, F.A.; Binsuwaidan, R.; Attallah, N.G.M.; Ahmed, E.; Magdeldin, S.; Al-Fakhrany, O.M. Evaluation of Tamarix nilotica Fractions in Combating Candida albicans Infections. Expert Rev. Anti-Infect. Ther. 2024, 22, 241–251. [Google Scholar] [CrossRef] [PubMed]
- Zhang, S.; Wang, L.; Liang, X.; Vorstius, J.; Keatch, R.; Corner, G.; Nabi, G.; Davidson, F.; Gadd, G.M.; Zhao, Q. Enhanced Antibacterial and Antiadhesive Activities of Silver-PTFE Nanocomposite Coating for Urinary Catheters. ACS Biomater. Sci. Eng. 2019, 5, 2804–2814. [Google Scholar] [CrossRef] [PubMed]
- Khan, M.I.; Xu, S.; Ali, M.M.; Ali, R.; Kazmi, A.; Akhtar, N.; Bilal, M.; Hu, Y.; Li, F. Assessment of Multidrug Resistance in Bacterial Isolates from Urinary Tract-Infected Patients. J. Radiat. Res. Appl. Sci. 2020, 13, 267–275. [Google Scholar] [CrossRef]
- Tran, P.L.; Hamood, A.N.; Reid, T.W. Antimicrobial Coatings to Prevent Biofilm Formation on Medical Devices. In Antibiofilm Agents; Rumbaugh, K.P., Ahmad, I., Eds.; Springer: Berlin/Heidelberg, Germany, 2014; pp. 175–204. [Google Scholar] [CrossRef]
- Aleksandra, I.; Ivanova, K.; Perelshtein, I.; Gedanken, A.; Tzanov, K.; Mileva, R.; Petar, D.; Teodora, P.; Tzanko, T. Sonochemically Engineered Nano-Enabled Zinc Oxide/Amylase Coatings Prevent the Occurrence of Catheter-Associated Urinary Tract Infections. Mater. Sci. Eng. C 2021, 131, 112518. [Google Scholar] [CrossRef]
- Rahuman, H.B.H.; Dhandapani, R.; Palanivel, V.; Thangavelu, S.; Paramasivam, R.; Muthupandian, S. Bioengineered Phytomolecules-Capped Silver Nanoparticles Using Carissa carandas Leaf Extract to Embed Onto Urinary Catheter to Combat UTI Pathogens. PLoS ONE 2021, 16, e0256748. [Google Scholar] [CrossRef]
- Jia, L.L.; Patrick, H.K.; Tambyah, L.E.; Kimberly, A.K.; Wean, C.S.; Susanna, S.S.J. Development of a Polymer-Based Antimicrobial Coating for Efficacious Urinary Catheter Protection. Biotechnol. Notes 2021, 2, 1–10. [Google Scholar] [CrossRef]

| Peak No. | Retention Time | Peak Area % | Height % | Compound Name | Structure |
|---|---|---|---|---|---|
| 1 | 16.969 | 12.42 | 11.82 | Diethyl phthalate | ![]() |
| 2 | 20.148 | 14.53 | 17.73 | Pentadecanoic acid | ![]() |
| 3 | 21.670 | 24.91 | 31.24 | Methyl 6,11-octadecadienoate | ![]() |
| 4 | 21.700 | 33.16 | 29.54 | Cyclopropaneoctanoic acid, 2-[(2-pentylcyclopropyl)methyl]-methyl ester, trans | ![]() |
| 5 | 25.950 | 14.98 | 9.67 | Erythro-7,8-bromochlorodisparlure | ![]() |
Disclaimer/Publisher’s Note: The statements, opinions and data contained in all publications are solely those of the individual author(s) and contributor(s) and not of MDPI and/or the editor(s). MDPI and/or the editor(s) disclaim responsibility for any injury to people or property resulting from any ideas, methods, instructions or products referred to in the content. |
© 2024 by the authors. Licensee MDPI, Basel, Switzerland. This article is an open access article distributed under the terms and conditions of the Creative Commons Attribution (CC BY) license (https://creativecommons.org/licenses/by/4.0/).
Share and Cite
Karrar Alsharif, M.H.; Poyil, M.M.; Bin Dayel, S.; Alqahtani, M.S.; Albadrani, A.A.; Omar, Z.M.M.; Arafah, A.M.; Alarabi, T.G.M.; Fayyad, R.M.; Abd El-Lateef, A.E.-L.S. Eradication of Biofilms on Catheters: Potentials of Tamarix ericoides Rottl. Bark Coating in Preventing Catheter-Associated Urinary Tract Infections (CAUTIs). Life 2024, 14, 1593. https://doi.org/10.3390/life14121593
Karrar Alsharif MH, Poyil MM, Bin Dayel S, Alqahtani MS, Albadrani AA, Omar ZMM, Arafah AM, Alarabi TGM, Fayyad RM, Abd El-Lateef AE-LS. Eradication of Biofilms on Catheters: Potentials of Tamarix ericoides Rottl. Bark Coating in Preventing Catheter-Associated Urinary Tract Infections (CAUTIs). Life. 2024; 14(12):1593. https://doi.org/10.3390/life14121593
Chicago/Turabian StyleKarrar Alsharif, Mohammed H., Muhammad Musthafa Poyil, Salman Bin Dayel, Mohammed Saad Alqahtani, Ahmed Abdullah Albadrani, Zainab Mohammed M. Omar, Abdullah MR. Arafah, Tarig Gasim Mohamed Alarabi, Reda M. Fayyad, and Abd El-Lateef Saeed Abd El-Lateef. 2024. "Eradication of Biofilms on Catheters: Potentials of Tamarix ericoides Rottl. Bark Coating in Preventing Catheter-Associated Urinary Tract Infections (CAUTIs)" Life 14, no. 12: 1593. https://doi.org/10.3390/life14121593
APA StyleKarrar Alsharif, M. H., Poyil, M. M., Bin Dayel, S., Alqahtani, M. S., Albadrani, A. A., Omar, Z. M. M., Arafah, A. M., Alarabi, T. G. M., Fayyad, R. M., & Abd El-Lateef, A. E.-L. S. (2024). Eradication of Biofilms on Catheters: Potentials of Tamarix ericoides Rottl. Bark Coating in Preventing Catheter-Associated Urinary Tract Infections (CAUTIs). Life, 14(12), 1593. https://doi.org/10.3390/life14121593






